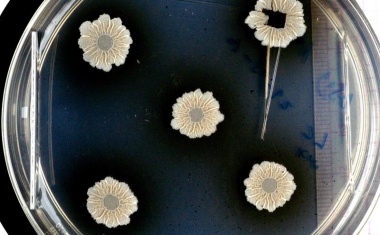
Photo

Gute Bakterien für böse Wunden
Empa-Forschende entwickeln einen Verband mit Milchsäurebakterien.

Empa-Forschende entwickeln einen Verband mit Milchsäurebakterien.

Infektionen mit dem Pilz Aspergillus fumigatus sind schwer zu bekämpfen – insbesondere, weil der Pilz einen Biofilm bildet und sich so vor Antimykotika und der Immunabwehr schützen kann. Das Krebsmedikament Imatinib verhindert die Abschottung.

Neues Biofilm-Modell zur Beurteilung der Effektivität von antimikrobiellen Substanzen gegen Wundbiofilm

Molekular-Mikroskopie ermöglicht als Brückentechnologie zwischen Molekularbiologie, Mikrobiologie und Pathologie eine deutlich schnellere und sensitivere Diagnostik für kritisch Kranke.
Ein internationales Team hat ein Modellsystem für Biofilme an der Synchrotronstrahlungsquelle BESSY II am HZB und der ESRF in Grenoble untersucht.






